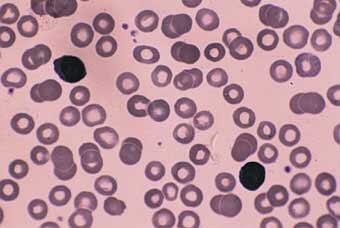

Des nutriments pour renforcer le système immunitaire et faire échec aux infections de l'hiver
| Le système immunitaire défend notre organisme notamment contre les agressions extérieures. L'efficacité de son système est dépendante du statut nutritionnel et les études montrent que chez les personnes ayant un faible statut nutritionnel ou souffrant de franche malnutrition, les défenses immunitaires sont perturbées. Elles sont alors plus vulnérables aux infections. Le système immunitaire décline avec l'âge et les premiers signes apparaissent lorsque le thymus commence à s'atrophier juste après la puberté. Des suppléments nutritionnels contenant des vitamines, des minéraux, des extraits de plantes voire certaines hormones permettent de renforcer l'efficacité du système immunitaire, de lutter contre les infections de l'hiver ou d'en alléger les symptômes. |
| Les cellules du système immunitaire
Les deux grandes armes du système immunitaire sont les anticorps et les lymphocytes. Les premiers protègent l'organisme contre les bactéries et les seconds contre les cellules modifiées. D'autres types cellulaires et moléculaires interviennent à leurs côtés dans les réactions immunologiques. |
| Des antioxydants pour soutenir la réponse immunitaire
De récentes études ont souligné le rôle joué par les antioxydants dans le traitement des maladies virales. |
 |
Non seulement ils réduisent les symptômes de la maladie mais également ils diminuent les effets à long terme du stress oxydant qui se développe chez les patients infectés par une grippe, un virus immuno-déficient ou une hépatite. |
|
D'autres études ont indiqué que des concentrations plus élevées de vitamine C augmentent, in vitro, les réponses des lymphocytes T. On a également montré que, in vitro, elle désactive virus et bactéries. |
|
|
|
Dans des études sur l'homme, des doses plus élevées que 100 g par jour ont été utilisées dans des cas d'infections bactériennes ou virales sévères. Dans une autre étude, des chercheurs italiens ont montré que deux grammes par jour d'acide ascorbique restauraient efficacement la réceptivité bronchique chez des travailleurs hospitaliers souffrant d'infection des voies respiratoires supérieures.1 |
|
La vitamine E est le premier antioxydant liposoluble et elle intervient de façon synergique et complémentaire avec la vitamine C. Alors que la vitamine E protège les lipoprotéines sériques et régule l'équilibre des prostaglandines, de récentes recherches suggèrent qu'elle pourrait renforcer la phagocytose, l'immunité à médiation cellulaire, l'immunité humorale et réduirait les effets du stress sur la réponse immunitaire. |
|
Dans une étude animale sur les maladies de cœur du sujet vieillissant, des souris âgées ont été nourries avec de la vitamine E pendant deux mois avant d'être exposées au virus de la grippe. Dans les poumons de ces animaux, on a trouvé des quantités nettement moins importantes de virus de la grippe que dans ceux des animaux témoins. |
 |
|
Le glutathion agit dans l'organisme comme un antioxydant particulièrement important en fournissant une défense intracellulaire contre le stress oxydant causé par les radicaux libres, les espèces oxygénées réactives intermédiaires ou certains produits chimiques toxiques. Le glutathion aide à recycler les vitamines C et E et à maintenir leurs niveaux dans les tissus. Le glutathion intervient également en détoxifiant le peroxyde d'hydrogène et d'autres organoperoxydases (des radicaux libres) protégeant ainsi contre une oxydation intracellulaire. |
| Des minéraux pour prévenir ou traiter
Le zinc est essentiel à l'intégrité du thymus comme à l'immunité à médiation cellulaire. Lorsque l'organisme n'a pas suffisamment de zinc, le système immunitaire ne fonctionne pas correctement. |
 |
Une étude6 de deux ans en double aveugle suggère ainsi que le zinc et le sélénium, pris ensemble à doses nutritionnelles, peuvent diminuer le nombre d'infections chez les résidents de maisons de retraite. |
| Le ginseng renforce l'efficacité du vaccin anti-grippe
Comme adaptogène, le ginseng, Panax ginseng ou quinquefolium, augmente la résistance au stress de l'organisme en soutenant la capacité de l'individu à lutter contre la maladie en renforçant sa vitalité globale et stimulant les fonctions normales de son organisme. Une étude montre que le ginseng prévient les symptômes du rhume et améliore la réponse des anticorps au vaccin contre la grippe. Pendant 12 semaines, 227 volontaires qui fréquentaient trois centres médicaux privés à Milan ont reçu quotidiennement 100 mg d'un extrait de Panax ginseng ou un placebo. Au cours de la quatrième semaine, ils ont été vaccinés contre la grippe. Dans le groupe qui avait pris du ginseng, il n'y a eu que 15 cas de grippe ou de rhume contre 42 dans le groupe placebo. À la huitième semaine, les anticorps atteignaient en moyenne 272 unités dans le groupe ayant pris du ginseng et seulement 171 dans le groupe témoin. |
|
Des études pré-cliniques ont montré qu'un extrait de ginseng américain (Panax quinquefolium) renforçait la réponse immunitaire en stimulant les cellules naturelles tueuses et les macrophages. Des études de laboratoire ont montré que chez des souris il augmente la prolifération des lymphocytes B, et la production par les macrophages de cytokines, d'interleukines et de l'oxyde nitrique, un produit antimicrobien. En présence de virus actif de la grippe, l'extrait de Panax quinquefolium stimule et augmente la production d'antigènes spécifiques. Des études cliniques ont montré qu'il diminue l'incidence des symptômes respiratoires induits par les rhumes et la grippe chez des personnes âgées en bonne santé8. |
 |
| Mélatonine et DHEA
La DHEA est une hormone stéroïdienne qui diminue radicalement avec le vieillissement. Elle régule à la baisse les récepteurs des glucocorticoïdes. Ces derniers étant imunosuppresseurs, le rôle immunostimulant de la DHEA est dû, au moins en partie, à son action anti-régulatrice qui s'oppose à celle des glucocorticoïdes. Des chercheurs ont souligné que la multiplication par quatre du ratio DHEAS/cortisol, en réponse à une dose de 50 mg de DHEA dans une cohorte d'hommes d'âge avancé, pourrait être considéré comme un milieu hormonal surrénal favorable à une stimulation du système immunitaire. |
 |
La 7-kéto-DHEA est une forme de DHEA qui a un effet beaucoup plus efficace sur le système immunitaire en particulier chez les femmes. Des chercheurs ont ainsi donné à des femmes ménopausées 50 mg de DHEA pendant trois semaines. Ils ont observé ensuite une augmentation très importante de la cytotoxicité des cellules tueuses naturelles ainsi qu'une très légère diminution des CD4. Dans une étude pilote réalisée à l'université du Wisconsin, la 7-Kéto DHEA augmentait plus efficacement la production de lymphocytes T que la DHEA et élevait davantage la production d'anticorps chez des souris auxquelles avait été administré un vaccin antigrippal que la DHEA. |
|
Différentes études sur l'homme et sur l'animal ont montré un effet stimulant de la mélatonine sue le système immunitaire, spécialement chez des animaux stressés, âgés ou malades. Une des fonctions de la mélatonine est, en effet, de stimuler la production des lymphocytes T ainsi que celles d'autres composantes de l'immunité comme les cellules naturelles tueuses, des interleukines ou des gamma-interférons. Des chercheurs ont noté qu'un traitement régulier de souris âgées avec de la mélatonine restaurait un certain nombre d'altérations immunitaires liées à l'âge. En particulier, au niveau du thymus, un re-développement de l'organe était observé. |
1. Effect of ascorbic acid on increased bronchial responsiveness during upper airway infections. Bucca C., et al., Respiration 1989 ; 55 : 214-219. 2. Does vitamin C alleviate the symptoms of the common cold: A review of current evidences. Hemilä H. Scand J Infec Dis 1994; 26: 1-6. 3. Effect of vitamin and trace elements supplementation on immune indices in healthy elderly. Pike J et al. International journal of Vitamins and Nutrition Research, 1995; 65:117-20. 4. Inhibition of influenza infection by glutathione. Cai et al., Free rad Biol Med 31(7): 928-36, 2003. 5. Effect of micronutrients supplementation on infection in institutionalised elderly subjects: a controlled trial. Girodonf F. et al., Ann Nutr Metab 1997; 135: 689-697. 6. Zinc gluconate lozenges for treating the common cold: a randomised, double-blind, placebo controlled study. Mossad SB. Et al Ann Intern Med. 1996;125:81-88. 7. Efficacy and safety of the standardized ginseng extract G115 for potentiating vaccination against common cold and/or influenza syndrome, Scaglione F., et al., Drugs experimental and clinical research. 1996; 22(2); 65-72. 8. A double blind, placebo controlled study of CVT-E002 in immunocompetent community dwelling adults aged 65 years or older. University of Alberta, Internal Clinical report, 1999. |

Une forme non acide de Vitamine C brevetée, conçue pour durer plus longtemps
test.supersmart.comTous droits de reproduction réservés
Gratuit
Merci de votre visite, avant de partir
inscrivez-vous auClub SuperSmart
d'avantages exclusifs:
- Gratuit : la publication hebdomadaire scientifique "Nutranews"
- Des promotions exclusives aux membres du club



 Format PDF
Format PDF

















